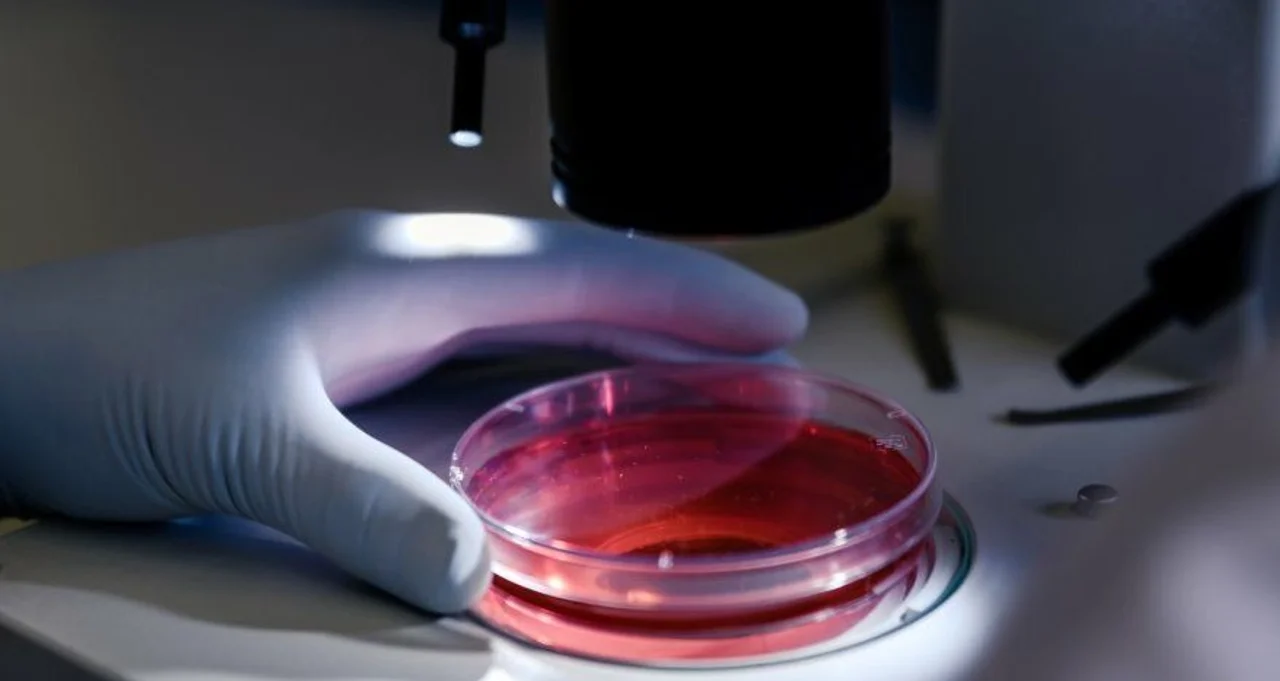
720 (10)

Es posible detectar el riesgo de leucemia con un examen de sangre
Investigadores encontraron que un simple examen de sangre puede detectar el riesgo de una persona de desarrollar leucemia, se indicó hoy en una declaración del Instituto Weizmann de Ciencias de Israel.
En un nuevo estudio, publicado en Nature Medicine, un equipo de investigadores israelíes y estadounidenses señalaron que este examen podría reemplazar el actual y más invasivo método de tomar una muestra de la médula ósea empleado para diagnosticar ciertos tipos de cáncer en la sangre.
La investigación se centró en el síndrome mielodisplásico (SMD), una afección relacionada con la edad en el que las células madre que forman la sangre no se desarrollan correctamente.
El SMD puede conducir a una anemia severa y progresar hasta convertirse en leucemia mieloide, uno de los tipos más comunes de cáncer en la sangre en adultos.
En la actualidad, diagnosticar el SMD requiere un procedimiento para tomar una muestra de la médula ósea, lo cual implica anestesia local y puede provocar una incomodidad y dolor significativos.
El equipo descubrió que células madre poco comunes, que ocasionalmente salen de la médula ósea y entran al torrente sanguíneo, llevan consigo información crucial sobre signos tempranos de SMD.
Empleando la secuenciación genética de una sola célula, los investigadores pudieron analizar estas células a partir de una muestra estándar de sangre y detectar signos de advertencia de la enfermedad.
Los investigadores encontraron además que estas células madre en circulación pueden actuar como un "reloj" biológico que ofrece información sobre la edad cronológica de una persona.
En los hombres, estas células cambian de manera más temprana que en las mujeres, lo cual podría contribuir a explicar por qué los cánceres de sangre son más comunes en hombres.
Los investigadores consideran que este examen de sangre también podría ayudar a identificar en el futuro otras afecciones sanguíneas relacionadas con la edad.
El Instituto Weizmann de Ciencias señaló que estos hallazgos están siendo probados en una prueba clínica a gran escala en centros médicos de todo el mundo.


Lula critica la guerra contra Irán y apunta a los líderes que actúan como "dueños del mundo"
20/03/2026




Murió Chuck Norris a los 86 años
20/03/2026
Gastos en servicios públicos: en el AMBA supera, en promedio, los $213.000 mensuales por hogar
20/03/2026


